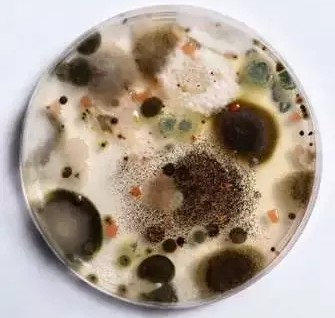
粉末涂料抗菌剂应用与防霉性能案例分享 涂料在线,coatingol.com

抗菌材料发展趋势
自1998年起,抗菌剂产业至2016年已经发展成为1500亿产业。


抗菌剂在粉末涂料的应用研究
有机抗菌防霉剂包含抗细菌,防霉,防藻功能。
例如三氯生、OBPA、IPBC、OIT、DCOIT、BBIT、 folpet 、DBDCB、有机锌盐、有机铜盐等抗菌防霉剂涂料在线coatingol.com。
有机抗菌防霉剂:
优 点:有机系小分子杀菌剂具有初始杀菌力强、杀菌即效和抗菌谱广谱等优点,而且无论是粉状还是液体都比较容易分散到树脂去,合成技术比较成熟,价格相对便宜。缺 点:耐热性和安全性方面弱于无机抗菌剂。
天然抗菌剂由于杀菌效果一般,易分解,耐热性较差,基本上不予采用。
银离子抗菌剂-LD904
LD904/LD940/ZN90 是以银锌离子为活性组分的抗菌剂
外观:白色粉末气味:极低气味耐高温:加工时可短时承受 400℃以下温度